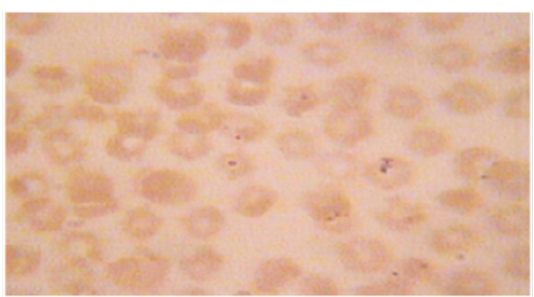

Advances in Animal and Veterinary Sciences
Research Article
Adv. Anim. Vet. Sci. 6(4): 176-182
Figure 1
Microscopic pictures of Anaplasma spp in thin blood smear (100x).
Figure 2
Microscopic picture of Babesia spp in thin blood smear (100x).
Figure 3
PCR products amplified using bab-F & bab-R specific primers. Lane M: 100 bp DNA ladder, lane N: negative control, lane: S74, S31, S7,S44 positive samples.
Figure 4
PCR products amplified using AE1-F & AE1-R specific primers. Lane M: 100 bp DNA ladder, lane N: Negative control, lane: S37, S52, S72, S4, S2 positive samples.